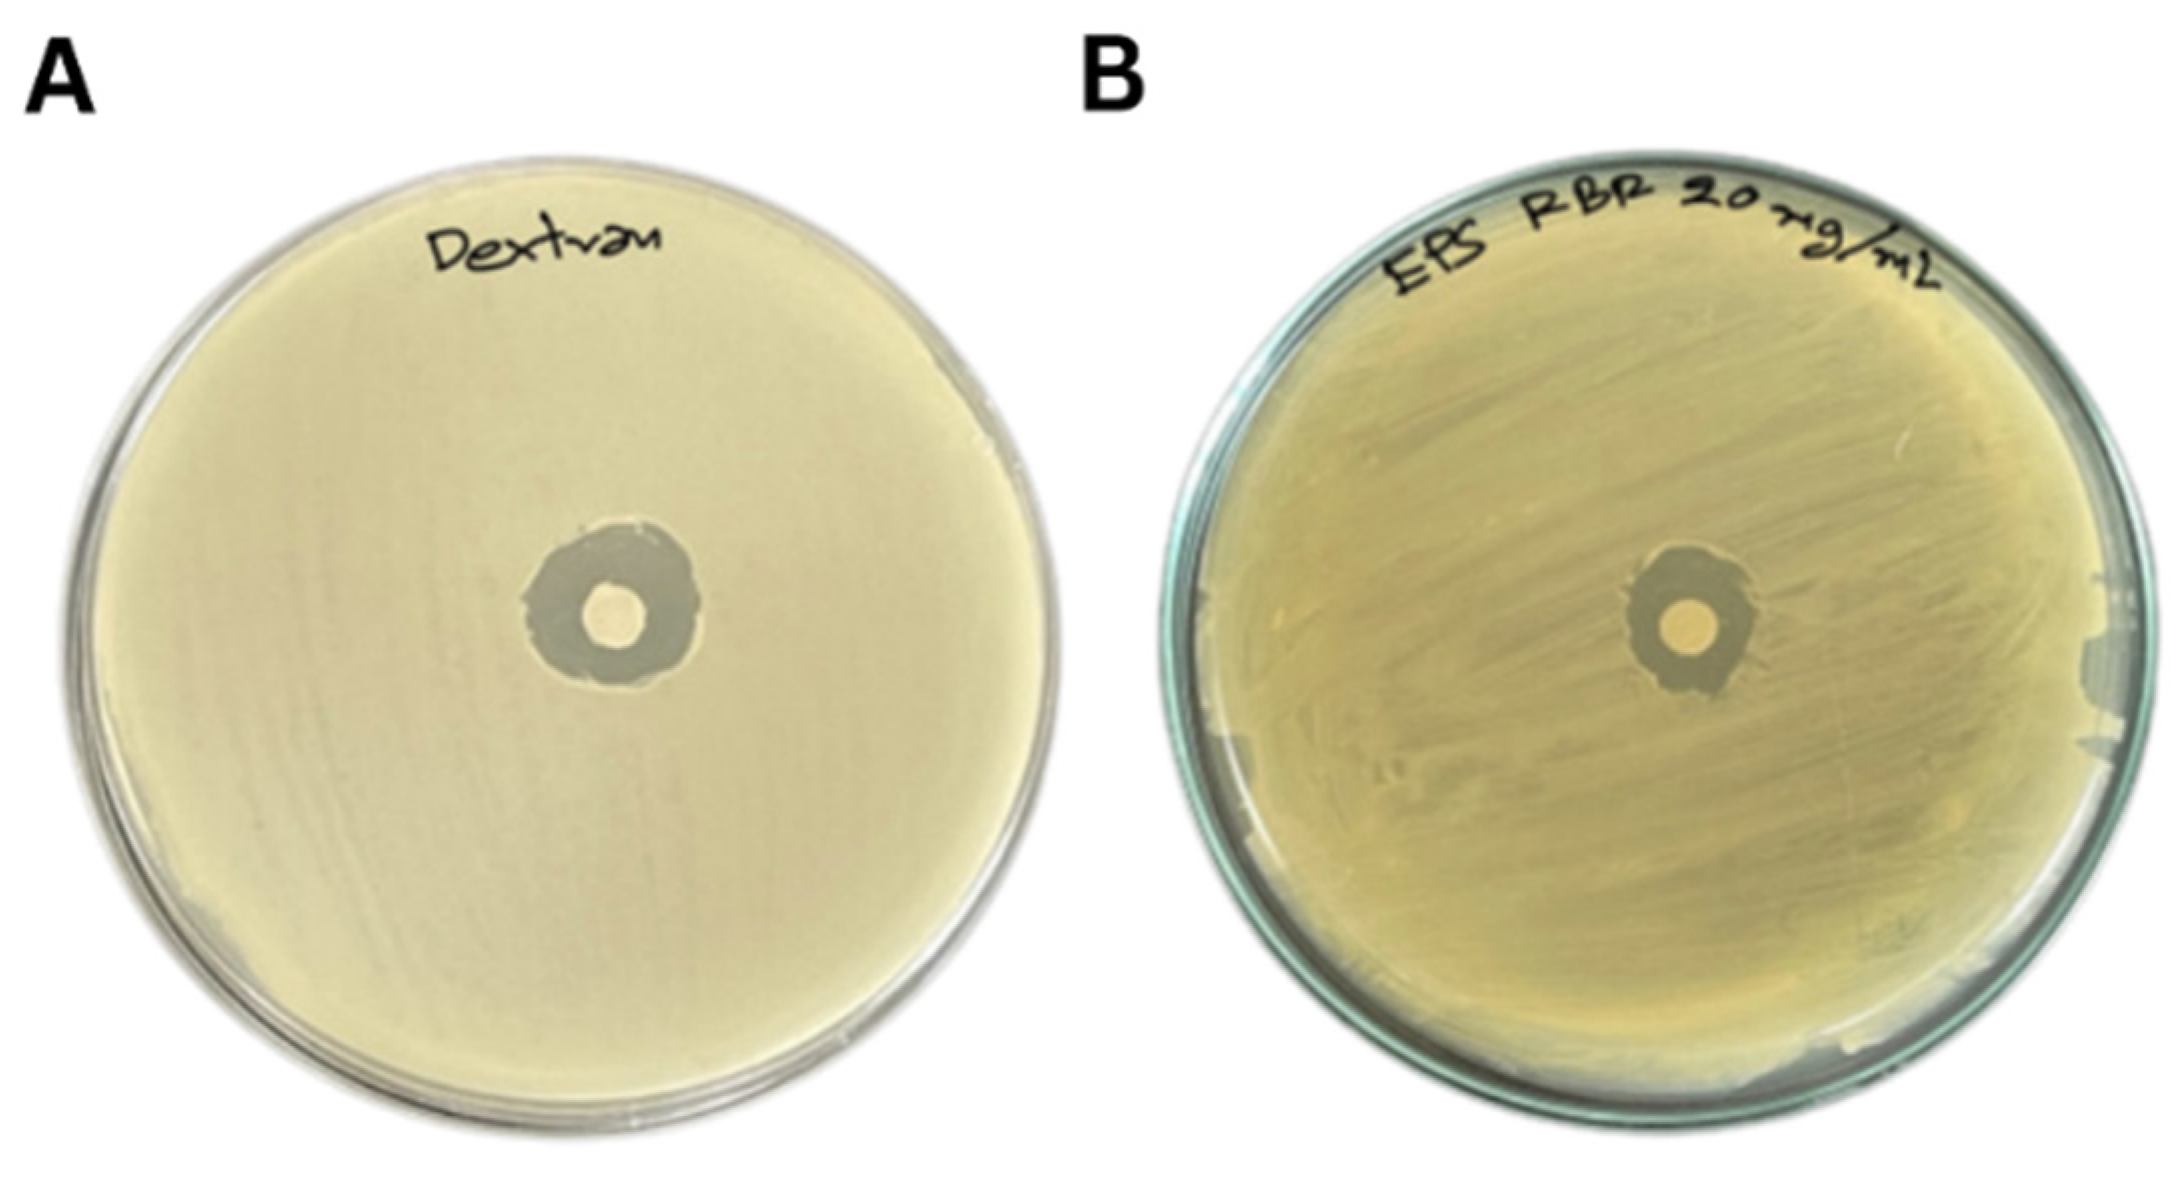
Animals 13 03262 g002

Dietary Administration Effects of Exopolysaccharide Produced by Bacillus tequilensis PS21 Using Riceberry Broken Rice, and Soybean Meal on Growth Performance, Immunity, and Resistance to Streptococcus agalactiae of Nile tilapia (Oreochromis niloticus)
Abstract
:Simple Summary
Abstract
1. Introduction
2. Materials and Methods
2.1. Bacterial Cultivation
2.2. Bacterial EPS Production
2.3. Crude EPS Extraction and Compositional Analysis
2.4. Monosaccharide Composition Analysis
2.5. Fourier-Transform Infrared Spectroscopy (FTIR) Analysis
2.6. Scanning Electron Microscopic (SEM) Analysis
2.7. Antioxidant Activity Assays
2.7.1. Scavenging Ability on 2,2-Diphenyl-1-picrylhydrazyl (DPPH•) Free Radicals
2.7.2. Ferric Ion Antioxidant Reducing Power (FRAP)
2.7.3. Scavenging Ability on Hydroxyl Radicals
2.8. Antimicrobial Activity of EPS
2.9. Trial Fish Diet Formula
2.10. Experimental Design
2.11. Sample Collections
2.12. Growth Measurements
2.13. Body Chemical Composition and Organosomatic Indices
2.14. Blood Chemical Analysis and Antioxidant Enzyme Activity
2.15. Hematological Parameters
2.16. Immunological Analysis
2.17. Serum Bactericidal Activity
2.18. Gene Expression
2.19. Challenge Test
2.20. Statistical Analysis
3. Results
3.1. EPS Characterization
3.2. EPS Bioactivities
3.3. Growth Performances
3.4. Hematological and Blood Chemical Profiles
3.5. Body Composition and Organosomatic Indices
3.6. Blood Biochemical Profiles and Immunological/Antioxidant Parameters
3.7. Gene Expressions in the Spleen and Liver
3.8. Bactericidal Activity
3.9. Pathogen Challenge Test
4. Discussion
5. Conclusions
Author Contributions
Funding
Institutional Review Board Statement
Data Availability Statement
Acknowledgments
Conflicts of Interest
References
- FAO. Oreochromis niloticus Linnaeus, 1758, Fisheries and Aquaculture Division. Available online: https://www.fao.org/fishery/en/aqspecies/tln (accessed on 12 May 2023).
- De Sousa, E.L.; Assane, I.M.; Santos-Filho, N.A.; Cilli, E.M.; de Jesus, R.B.; Pilarski, F. Haematological, biochemical and immunological biomarkers, antibacterial activity, and survival in Nile tilapia Oreochromis niloticus after treatment using antimicrobial peptide LL-37 against Streptococcus agalactiae. Aquaculture 2021, 533, 736181. [Google Scholar] [CrossRef]
- Okocha, R.C.; Olatoye, I.O.; Adedeji, O.B. Food safety impacts of antimicrobial use and their residues in aquaculture. Public Health Rev. 2018, 39, 21. [Google Scholar] [CrossRef]
- Hong, B.; Ba, Y.; Niu, L.; Lou, F.; Zhang, Z.; Liu, H.; Pan, Y.; Zhao, Y. A comprehensive research on antibiotic resistance genes in microbiota of aquatic animals Front. Microbiol. 2018, 9, 1617. [Google Scholar]
- Bae, J.; Hamidoghli, A.; Won, S.; Choi, W.; Lim, S.G.; Kim, K.W.; Lee, B.-J.; Hur, S.-W.; Bai, S.C. Evaluation of seven different functional feed additives in a low fish meal diet for olive flounder, Paralichthys olivaceus. Aquaculture 2020, 525, 735333. [Google Scholar] [CrossRef]
- Wangkahart, E.; Bruneel, B.; Chantiratikul, A.; de Jong, M.; Pakdeenarong, N.; Subramani, P.A. Optimum dietary sources and levels of selenium improve growth, antioxidant status, and disease resistance: Re-evaluation in a farmed fish species, Nile tilapia (Oreochromis niloticus). Fish Shellfish Immunol. 2022, 121, 172–182. [Google Scholar] [CrossRef]
- Mahdhi, A.; Chakroun, I.; Espinosa-Ruiz, C.; Messina, C.M.; Arena, R.; Majdoub, H.; Santulli, A.; Mzoughi, R.; Esteban, M.A. Dietary administration effects of exopolysaccharide from potential probiotic strains on immune and antioxidant status and nutritional value of European sea bass (Dicentrarchus labrax L.). Res. Vet. Sci. 2020, 131, 51–58. [Google Scholar] [CrossRef]
- Marudhupandi, T.; Inbakandan, D. Polysaccharides in aquatic disease management. Fish. Aquac. J. 2015, 6, 135. [Google Scholar] [CrossRef]
- Luang-In, V.; Deeseenthum, S. Exopolysaccharide-producing isolates from Thai milk kefir and their antioxidant activities. LWT 2016, 73, 592–601. [Google Scholar] [CrossRef]
- Luang-In, V.; Saengha, W.; Deeseenthum, S. Characterization and bioactivities of a novel exopolysaccharide produced from lactose by Bacillus tequilensis PS21 isolated from Thai milk kefir. Microbiol. Biotechnol. Lett. 2018, 46, 9–17. [Google Scholar] [CrossRef]
- Luang-In, V.; Yotchaisarn, M.; Somboonwatthanakul, I.; Deeseenthum, S. Bioactive compounds and bioactivities of organic Thai riceberry rice by-product extracts. Thai J. Pharm. Sci. 2018, 42, 161–168. [Google Scholar]
- Abinaya, M.; Shanthi, S.; Palmy, J.; Al-Ghanim, K.A.; Govindarajan, M.; Vaseeharan, B. Exopolysaccharides-mediated ZnO nanoparticles for the treatment of aquatic diseases in freshwater fish Oreochromis mossambicus. Toxics 2023, 11, 313. [Google Scholar] [CrossRef] [PubMed]
- Feng, J.; Cai, Z.; Chen, Y.; Zhu, H.; Chang, X.; Wang, X.; Liu, Z.; Zhang, J.; Nie, G. Effects of an exopolysaccharide from Lactococcus lactis Z-2 on innate immune response, antioxidant activity, and disease resistance against Aeromonas hydrophila in Cyprinus carpio L. Fish Shellfish Immunol. 2020, 98, 324–333. [Google Scholar] [CrossRef] [PubMed]
- Zhang, L.; Liu, C.; Li, D.; Zhao, Y.; Zhang, X.; Zeng, X.; Yang, Z.; Li, S. Antioxidant activity of an exopolysaccharide isolated from Lactobacillus plantarum C88. Int. J. Biol. Macromol. 2013, 54, 270–275. [Google Scholar] [CrossRef] [PubMed]
- Karirat, T.; Saengha, W.; Deeseenthum, S.; Luang-In, V. Riceberry Broken Rice and Soybean Meal as Substrates for Exopolysaccharide Production by Bacillus tequilensis PS21. In Proceedings of the 8th International Conference on Food, Agriculture and Biotechnology, Virtual Conference, 5–6 August 2021. [Google Scholar]
- Paulo, E.M.; Boffo, E.F.; Branco, A.; Valente, A.M.; Melo, I.S.; Ferreira, A.G.; Roque, M.R.A.; de Assis, S.A. Production, extraction and characterization of exopolysaccharides produced by the native Leuconostoc pseudomesenteroides R2 strain. An. Acad. Bras. Cienc. 2012, 84, 495–508. [Google Scholar] [CrossRef]
- Lowry, O.H.; Rosebrough, N.J.; Farr, A.L.; Randall, R.J. Protein measurement with the Folin phenol reagent. J. Biol. Chem. 1951, 193, 265–275. [Google Scholar] [CrossRef]
- Dubois, M.; Gilles, K.A.; Hamilton, J.K.; Rebers, P.A.; Sith, F. Calorimetric method for determination of sugars and related substances. Anal. Chem. 1956, 28, 350–356. [Google Scholar] [CrossRef]
- Glasel, J. Validity of nucleic acid purities monitored by 260/280 absorbance ratios. Biotechniques 1995, 18, 62–63. [Google Scholar]
- Blois, M.S. Antioxidant determinations by the use of a stable free radical. Nature 1958, 181, 1199–1200. [Google Scholar] [CrossRef]
- Desmarchelier, C.; Bermudez, M.J.N.; Coussio, J.; Ciccia, G.; Boveris, A. Antioxidant and prooxidant activities in aqueous extract of Argentine plants. Int. J. Pharmacogn. 1997, 35, 116–120. [Google Scholar] [CrossRef]
- Benzie, I.F.; Strain, J.J. The ferric reducing ability of plasma (FRAP) as a measure of “antioxidant power”: The FRAP assay. Anal. Biochem. 1996, 239, 70–76. [Google Scholar] [CrossRef]
- Halliwell, B.; Gutteridge, J.M.C. Free Radicals in Biology and Medicine; Clarendon Press: Oxford, UK, 1989; Volume 3, pp. 617–783. [Google Scholar]
- Luang-In, V.; Yotchaisarn, M.; Saengha, W.; Udomwong, P.; Deeseenthum, S.; Maneewan, K. Isolation and identification of amylase-producing bacteria from soil in Nasinuan Community Forest, Maha Sarakham, Thailand. Biomed. Pharmacol. J. 2019, 12, 1061–1068. [Google Scholar] [CrossRef]
- AOAC. Official Methods of Analysis of AOAC International, 16th ed.; Association of Official Analytical Chemists: Washington, DC, USA, 1995. [Google Scholar]
- Aengwanich, W.; Kongbuntad, W.; Boonsorn, T. Effects of shade on physiological changes, oxidative stress, and total antioxidant power in Thai Brahman cattle. Int. J. Biometeorol. 2011, 55, 741–748. [Google Scholar] [CrossRef] [PubMed]
- Mansour, A.T.; Goda, A.A.; Omar, E.A.; Khalil, H.S.; Esteban, M.Á. Dietary supplementation of organic selenium improves growth, survival, antioxidant and immune status of meagre, Argyrosomus regius, juveniles. Fish Shellfish Immunol. 2017, 68, 516–524. [Google Scholar] [CrossRef]
- Aebi, H. Catalase. In Methods in Enzymatic Analysis, 1st ed.; Bergmeyer, H.V., Ed.; Academic Press Inc.: New York, NY, USA, 1974; pp. 673–686. [Google Scholar]
- Houston, A.H.; DeWilde, M.A. Thermoacclimatory variations in the haematology of the common carp, Cyprinus carpio. J. Exp. Biol. 1968, 49, 71–81. [Google Scholar] [CrossRef]
- Van-Kampen, E.J.; Zijlstra, W.G. Standardization of hemoglobinometery. Clin. Chim. Acta 1961, 6, 438–544. [Google Scholar] [CrossRef] [PubMed]
- Sutthi, N.; Van Doan, H. Saccharomyces crevices and Bacillus spp. effectively enhance health tolerance of Nile tilapia under transportation stress. Aquaculture 2020, 528, 735527. [Google Scholar] [CrossRef]
- Abdel-Tawwab, M.; Abdel-Rahman, A.M.; Ismael, N.E.M. Evaluation of commercial live bakers’ yeast, Saccharomyces cerevisiae as a growth and immunity promoter for Fry Nile tilapia, Oreochromis niloticus (L.) challenged in situ with Aeromonas hydrophila. Aquaculture 2008, 280, 185–189. [Google Scholar] [CrossRef]
- Livak, K.J.; Schmittgen, T.D. Analysis of relative gene expression data using real-time quantitative PCR and the 2−ΔΔCT method. Methods 2001, 25, 402–408. [Google Scholar] [CrossRef]
- Van Doan, H.; Tapingkae, W.; Chaiyaso, T.; Wangkahart, E.; Panchan, R.; Sutthi, N. Effects of red yeast (Sporidiobolus pararoseus) on growth, innate immunity, expression of immune-related genes and disease resistance of Nile tilapia (Oreochromis niloticus). Probiotics Antimicrob. Proteins 2023, 15, 1312–1326. [Google Scholar] [CrossRef]
- Amend, D.F. Potency testing of fish vaccines. Dev. Biol. Stand. 1981, 49, 8. [Google Scholar]
- Santanam, N.; Ramachandran, S.; Parthasarathy, S. Oxygen radicals, antioxidants, and lipid peroxidation. Semin. Reprod. Med. 1998, 16, 275–280. [Google Scholar] [CrossRef] [PubMed]
- Dawood, M.A.O. Nutritional immunity of fish intestines: Important insights for sustainable aquaculture. Rev. Aquacult. 2021, 13, 642–663. [Google Scholar] [CrossRef]
- Vijayaram, S.; Sun, Y.Z.; Zuorro, A.; Ghafarifarsani, H.; Van Doan, H.; Hoseinifar, S.H. Bioactive immunostimulants as health-promoting feed additives in aquaculture: A review. Fish Shellfish Immunol. 2022, 130, 294–308. [Google Scholar] [CrossRef]
- Hu, G.; Wang, Y.; Xue, R.; Liu, T.; Zhou, Z.; Yang, Z. Effects of the exopolysaccharide from Lactiplantibacillus plantarum HMX2 on the growth performance, immune response, and intestinal, microbiota of juvenile Turbot, Scophthalmus maximus. Foods 2023, 12, 2051. [Google Scholar] [CrossRef]
- Moghannem, S.A.M.; Farag, M.M.S.; Shehab, A.M.; Azab, M.S. Exopolysaccharide production from Bacillus velezensis KY471306 using statistical experimental design. Braz. J. Microbiol. 2018, 49, 452–462. [Google Scholar] [CrossRef]
- Zheng, J.Q.; Wang, J.Z.; Shi, C.W.; Mao, D.B.; He, P.X.; Xu, C.P. Characterization and antioxidant activity for exopolysaccharide from submerged culture of Boletus aereus. Process Biochem. 2014, 49, 1047–1053. [Google Scholar] [CrossRef]
- Hu, Y.Q.; Wei, W.; Gao, M.; Zhou, Y.; Wang, G.X.; Zhang, Y. Effect of pure oxygen aeration on extracellular polymeric substances (EPS) of activated sludge treating saline wastewater. Process Saf. Environ. Prot. 2019, 123, 344–350. [Google Scholar] [CrossRef]
- Hasheminya, S.M.; Dehghannya, J. Novel ultrasound-assisted extraction of kefiran biomaterial, a prebiotic exopolysaccharide, and investigation of its physicochemical, antioxidant and antimicrobial properties. Mater. Chem. Phys. 2020, 243, 122645. [Google Scholar] [CrossRef]
- Wu, M.H.; Pan, T.M.; Wu, Y.J.; Chang, S.J.; Chang, M.S.; Hu, C.Y. Exopolysaccharide activities from probiotic bifidobacterium: Immunomodulatory effects (on J774A. 1 macrophages) and antimicrobial properties. Int. J. Food Microbiol. 2010, 144, 104–110. [Google Scholar] [CrossRef]
- Wan, A.A.Q.I.; Taufek, N.M.; Thiran, J.P.; Rahman, J.F.P.; Yerima, G.; Subramaniam, K.; Rowan, N. Investigations on the use of exopolysaccharide derived from mycelial extract of Ganoderma lucidum as functional feed ingredient for aquaculture-farmed red hybrid Tilapia (Oreochromis sp.). Future Foods 2021, 3, 100018. [Google Scholar]
- Fazio, F. Fish hematology analysis as an important tool of aquaculture: A review. Aquaculture 2019, 500, 237–242. [Google Scholar] [CrossRef]
- Liu, W.; Lu, X.; Jiang, M.; Wu, F.; Tian, J.; Yu, L.; Wen, H. Effects of dietary niacin on liver health in genetically improved farmed tilapia (Oreochromis niloticus). Aquac. Rep. 2020, 16, 100243. [Google Scholar] [CrossRef]
- Ellis, A.E. Innate host defense mechanisms of fish against viruses and bacteria. Dev. Comp. Immunol. 2001, 25, 827–839. [Google Scholar] [CrossRef] [PubMed]
- Rajeshkumar, N.V.; Kuttan, R. Modulation of carcinogenic response and antioxidant enzymes of rats administered with 1,2-dimethylhydrazine by Picroliv. Cancer Lett. 2003, 91, 137–143. [Google Scholar] [CrossRef]
- Newaj-Fyzul, A.; Adesiyun, A.A.; Mutani, A.; Ramsubhag, A.; Brunt, J.; Austin, B. Bacillus subtilis AB1controls Aeromonas infection in rainbow trout (Oncorhynchus mykiss, Walbaum). J. Appl. Microbiol. 2007, 103, 1699–1706. [Google Scholar] [CrossRef] [PubMed]
- Salinas, I.; Abelli, L.; Bertoni, F.; Picchietti, S.; Roque, A.; Furones, D.; Cuesta, A.; Meseguer, J.; Esteban, M.Á. Monospecies and multispecies probiotic formulations produce different systemic and local immunostimulatory effects in the gilthead seabream (Sparus aurata L.). Fish Shellfish Immunol. 2008, 25, 114–123. [Google Scholar] [CrossRef] [PubMed]
- Reverter, M.; Bontemps, N.; Lecchini, D.; Banaigs, B.; Sasal, P. Use of plant extracts in fish aquaculture as an alternative to chemotherapy: Current status and future perspectives. Aquaculture 2014, 433, 50–61. [Google Scholar] [CrossRef]
- Li, J.Z.; Li, Q.K.; Shan, A.S. Biological activities of exopolysaccharides produced by lactic acid bacteria and its application prospect in livestock production. Chin. J. Anim. Nutr. 2021, 33, 1901–1912. [Google Scholar]

| Gene | Accession No. | Primer Sequence (5′→3′) | Tm (°C) | Product Size (bp) |
|---|---|---|---|---|
| β-actin | EF206801 | Forward: GCTACTCCTTCACCACCACAG Reverse: CGTCAGGCAGCTCGTAACTC | 58 | 138 |
| IL-1β | JF957370 | Forward: TGCACTGTCACTGACAGCCAA Reverse: ATGTTCAGGTGCACTTTGCGG | 58 | 144 |
| TNF-α | AY428948 | Forward: CCAGAAGCACTAAAGGCGAAGA Reverse: CCTTGGCTTTGCTGCTGATC | 58 | 82 |
| Sample | Content (mg/g EPS) | EPS Production (g/100 mL) | ||
|---|---|---|---|---|
| Carbohydrate | Protein | Nucleic Acid | ||
| EPS | 404.23 ± 9.86 a (76.58%) | 15.66 ± 0.61 c (2.97%) | 107.92 ± 4.58 b (20.45%) | 2.40 ± 0.20 |
| Sample | DPPH Radical Scavenging Activity (%) | FRAP Value (mg FeSO4/g DW) | Hydroxyl Radical Scavenging Activity (%) | Inhibition Zone (mm Diameter) |
|---|---|---|---|---|
| EPS (20 mg/mL) | 65.50 ± 0.31 b | 2.07 ± 0.04 a | 80.53 ± 0.87 a | 14.17 ± 0.76 b |
| Dextran (20 mg/mL) | 73.98 ± 0.27 a | 2.23 ± 0.04 a | 80.94 ± 0.46 a | 15.50 ± 0.05 a |
| Chemical Composition | T1 (0.0 g/kg) | T2 (0.1 g/kg) | T3 (0.2 g/kg) | T4 (1.0 g /kg) | T5 (2.0 g/kg) |
|---|---|---|---|---|---|
| Crude protein (%) | 32.68 | 32.16 | 32.38 | 31.97 | 32.75 |
| Crude lipid (%) | 4.13 | 4.17 | 4.29 | 4.74 | 4.31 |
| Crude fiber (%) | 4.47 | 4.35 | 4.29 | 4.61 | 4.48 |
| Moisture (%) | 12.23 | 12.95 | 12.82 | 13.08 | 12.73 |
| Ash (%) | 10.09 | 9.80 | 9.87 | 10.17 | 9.98 |
| NFE (%) 1 | 48.63 | 49.53 | 49.18 | 48.51 | 48.47 |
| GE (MJ/kg) 2 | 17.71 | 17.75 | 17.79 | 17.76 | 17.77 |
| Parameter | T1 (0.0 g/kg) | T2 (0.1 g/kg) | T3 (0.2 g/kg) | T4 (1.0 g/kg) | T5 (2.0 g/kg) |
|---|---|---|---|---|---|
| Initial body weight (IBW; g) | 15.23 ± 0.73 | 14.90 ± 0.34 | 15.20 ± 0.95 | 15.16 ± 1.19 | 15.20 ± 1.01 |
| Initial length (IL; cm) | 7.63 ± 0.15 | 7.56 ± 0.23 | 7.66 ± 0.11 | 7.73 ± 0.30 | 7.60 ± 0.17 |
| Final body weight (FBW; g) | 57.61 ± 2.73 | 57.81 ± 3.29 | 60.01 ± 3.03 | 61.75 ± 1.37 | 60.22 ± 2.20 |
| Final length (FL; cm) | 11.40 ± 0.09 | 11.41 ± 0.26 | 11.60 ± 0.43 | 11.73 ± 0.12 | 11.76 ± 0.20 |
| Weight gain (WG; g) | 42.39 ± 2.19 | 42.90 ± 3.08 | 44.83 ± 2.30 | 46.60 ± 1.67 | 45.00 ± 1.33 |
| Length gain (LG; cm) | 3.77 ± 0.15 | 3.83 ± 0.05 | 3.90 ± 0.34 | 4.00 ± 0.36 | 4.20 ± 0.10 |
| Average daily growth gain (ADG; g/day) | 0.68 ± 0.03 | 0.69 ± 0.05 | 0.72 ± 0.04 | 0.75 ± 0.03 | 0.73 ± 0.02 |
| Specific growth rate; SGR (%/day) | 2.14 ± 0.05 | 2.18 ± 0.07 | 2.22 ± 0.05 | 2.26 ± 0.13 | 2.21 ± 0.06 |
| Feed conversion ratio; (FCR) | 1.46 ± 0.03 | 1.51 ± 0.06 | 1.53 ± 0.04 | 1.47 ± 0.11 | 1.52 ± 0.20 |
| Survival rate (%) | 83.33 ± 6.66 | 88.88 ± 6.94 | 85.55 ± 6.93 | 92.22 ± 6.94 | 88.89 ± 10.71 |
| Parameter | T1 (0.0 g/kg) | T2 (0.1 g/kg) | T3 (0.2 g/kg) | T4 (1.0 g/kg) | T5 (2.0 g/kg) |
|---|---|---|---|---|---|
| RBC (×106 cells/mm3) | 2.10 ± 0.06 | 1.96 ± 0.11 | 2.10 ± 0.16 | 2.11 ± 0.29 | 2.02 ± 0.13 |
| Hemoglobin (g/dL) | 11.00 ± 2.98 | 9.53 ± 3.30 | 10.50 ± 1.73 | 11.66 ± 1.62 | 10.73 ± 0.66 |
| Haematocrit (%) | 33.00 ± 9.64 | 27.66 ± 9.50 | 31.00 ± 6.24 | 34.66 ± 4.16 | 31.33 ± 1.52 |
| WBC (×103 cells/mm3) | 5.82 ± 1.46 | 4.14 ± 0.82 | 5.91 ± 1.80 | 6.39 ± 3.31 | 6.55 ± 1.10 |
| Neutrophils (%) | 30.00 ± 5.29 b | 34.00 ± 1.58 b | 32.66 ± 7.50 ab | 38.66 ± 1.52 a | 39.00 ± 1.73 a |
| Eosinophils (%) | 1.33 ± 0.57 | 1.16 ± 0.28 | 1.00 ± 0.01 | 1.16 ± 0.76 | 1.33 ± 0.57 |
| Lymphocytes (%) | 62.00 ± 4.58 | 63.66 ± 7.09 | 65.00 ± 5.19 | 66.66 ± 5.85 | 68.66 ± 2.51 |
| Monocytes (%) | 2.66 ± 0.57 | 3.66 ± 1.52 | 4.66 ± 1.52 | 3.00 ± 1.00 | 4.00 ± 0.01 |
| MCV (fL) | 175.00 ± 1.00 | 169.00 ± 4.35 | 171.33 ± 1.52 | 168.66 ± 6.80 | 174.66 ± 2.51 |
| MCH (pg) | 54.96 ± 0.80 | 57.33 ± 5.00 | 57.76 ± 2.08 | 57.00 ± 1.01 | 57.50 ± 2.52 |
| MCHC (g/dL) | 31.43 ± 0.65 | 33.86 ± 2.11 | 33.70 ± 1.15 | 33.86 ± 0.90 | 32.86 ± 1.35 |
| Parameter | T1 (0.0 g/kg) | T2 (0.1 g/kg) | T3 (0.2 g/kg) | T4 (1.0 g/kg) | T5 (2.0 g/kg) |
|---|---|---|---|---|---|
| Crude protein (%) | 62.82 ± 8.18 | 64.70 ± 6.09 | 61.52 ± 6.14 | 65.06 ± 9.01 | 69.41 ± 8.22 |
| Crude lipid (%) | 4.14 ± 0.38 | 3.45 ± 0.23 | 3.87 ± 0.27 | 3.77 ± 0.03 | 3.68 ± 0.13 |
| Moisture (%) | 3.35 ± 0.07 | 3.23 ± 0.04 | 3.72 ± 0.05 | 3.35 ± 0.00 | 3.13 ± 0.01 |
| Ash (%) | 5.50 ± 0.25 | 5.59 ± 0.30 | 5.58 ± 0.11 | 4.64 ± 0.90 | 4.57 ± 0.30 |
| Fillet (%) | 33.48 ± 2.14 | 34.16 ± 0.46 | 35.48 ± 11.04 | 33.07 ± 2.24 | 35.55 ± 4.74 |
| Carcass (%) | 48.66 ± 2.70 | 46.12 ± 2.67 | 55.05 ± 2.13 | 50.56 ± 12.17 | 47.61 ± 4.91 |
| Hepatosomatic index (HIS; %) | 2.42 ± 0.58 | 2.62 ± 0.72 | 2.78 ± 0.91 | 2.62 ± 0.55 | 2.71 ± 0.53 |
| Viscerosomatic index (VSI; %) | 10.54 ± 1.77 | 10.91 ± 1.80 | 11.91 ± 3.57 | 10.47 ± 1.57 | 10.82 ± 1.32 |
| Spleenosomatic index (SSI; %) | 0.20 ± 0.05 | 0.18 ± 0.050 | .25 ± 0.13 | 0.27 ± 0.03 | 0.21 ± 0.03 |
| Parameter | T1 (0.0 g/kg) | T2 (0.1 g/kg) | T3 (0.2 g/kg) | T4 (1.0 g/kg) | T5 (2.0 g/kg) |
|---|---|---|---|---|---|
| Total protein (g/dL) | 2.66 ± 0.15 | 3.00 ± 0.26 | 2.70 ± 0.17 | 3.00 ± 0.36 | 2.90 ± 0.10 |
| Albumin (g/dL) | 0.83 ± 0.05 | 0.80 ± 0.10 | 0.80 ± 0.02 | 0.90 ± 0.10 | 0.86 ± 0.05 |
| Globulin (g/dL) | 1.83 ± 0.15 | 2.20 ± 0.17 | 1.90 ± 0.17 | 2.10 ± 0.26 | 2.03 ± 0.05 |
| Aspartate aminotransferase; AST (U/L) | 73.66 ± 14.70 | 56.33 ± 16.66 | 69.33 ± 13.12 | 36.33 ± 15.30 | 54.66 ± 19.32 |
| Alanine aminotransferase; ALT (U/L) | 39.33 ± 8.62 | 30.33 ± 16.01 | 48.33 ± 18.36 | 30.00 ± 10.15 | 55.66 ± 15.55 |
| Blood Urea Nitrogen; BUN (mg/dL) | 1.33 ± 0.57 | 1.50 ± 0.50 | 1.16 ± 0.28 | 1.33 ± 0.29 | 1.35 ± 0.57 |
| Cholesterol (mg/dL) | 123.66 ± 6.50 | 130.66 ± 10.21 | 117.33 ± 29.31 | 108.66 ± 21.34 | 134.00 ± 11.35 |
| Parameter | T1 (0.0 g/kg) | T2 (0.1 g/kg) | T3 (0.2 g/kg) | T4 (1.0 g/kg) | T5 (2.0 g/kg) |
|---|---|---|---|---|---|
| Lysozyme activity (U/mL) | 5.80 ± 2.77 b | 7.30 ± 2.10 b | 11.00 ± 2.54 a | 11.52 ± 2.21 a | 12.16 ± 1.68 a |
| Myeloperoxidase; MPO (OD450nm) | 2.00 ± 0.74 b | 1.76 ± 1.15 b | 2.59 ± 0.84 ab | 3.28 ± 0.17 a | 3.21 ± 0.19 a |
| Superoxide dismutase; SOD (U/g liver) | 10.20 ± 1.48 c | 14.20 ± 0.83 b | 11.60 ± 3.64 bc | 16.60 ± 2.40 b | 20.80 ± 3.49 a |
| Catalase activity; CAT (U/g liver) | 26.25 ± 9.27 c | 31.25 ± 9.88 bc | 39.06 ± 9.37 abc | 46.25 ± 11.35 a | 42.50 ± 5.22 ab |
| Malondialdehyde; MDA (µmol/L) | 77.82 ± 8.90 a | 77.35 ± 6.75 a | 82.88 ± 20.42 a | 75.94 ± 7.92 a | 92.39 ± 10.10 a |
Disclaimer/Publisher’s Note: The statements, opinions and data contained in all publications are solely those of the individual author(s) and contributor(s) and not of MDPI and/or the editor(s). MDPI and/or the editor(s) disclaim responsibility for any injury to people or property resulting from any ideas, methods, instructions or products referred to in the content. |
© 2023 by the authors. Licensee MDPI, Basel, Switzerland. This article is an open access article distributed under the terms and conditions of the Creative Commons Attribution (CC BY) license (https://creativecommons.org/licenses/by/4.0/).
Share and Cite
Sutthi, N.; Wangkahart, E.; Panase, P.; Karirat, T.; Deeseenthum, S.; Ma, N.L.; Luang-In, V. Dietary Administration Effects of Exopolysaccharide Produced by Bacillus tequilensis PS21 Using Riceberry Broken Rice, and Soybean Meal on Growth Performance, Immunity, and Resistance to Streptococcus agalactiae of Nile tilapia (Oreochromis niloticus). Animals 2023, 13, 3262. https://doi.org/10.3390/ani13203262
Sutthi N, Wangkahart E, Panase P, Karirat T, Deeseenthum S, Ma NL, Luang-In V. Dietary Administration Effects of Exopolysaccharide Produced by Bacillus tequilensis PS21 Using Riceberry Broken Rice, and Soybean Meal on Growth Performance, Immunity, and Resistance to Streptococcus agalactiae of Nile tilapia (Oreochromis niloticus). Animals. 2023; 13(20):3262. https://doi.org/10.3390/ani13203262
Chicago/Turabian StyleSutthi, Nantaporn, Eakapol Wangkahart, Paiboon Panase, Thipphiya Karirat, Sirirat Deeseenthum, Nyuk Ling Ma, and Vijitra Luang-In. 2023. "Dietary Administration Effects of Exopolysaccharide Produced by Bacillus tequilensis PS21 Using Riceberry Broken Rice, and Soybean Meal on Growth Performance, Immunity, and Resistance to Streptococcus agalactiae of Nile tilapia (Oreochromis niloticus)" Animals 13, no. 20: 3262. https://doi.org/10.3390/ani13203262
APA StyleSutthi, N., Wangkahart, E., Panase, P., Karirat, T., Deeseenthum, S., Ma, N. L., & Luang-In, V. (2023). Dietary Administration Effects of Exopolysaccharide Produced by Bacillus tequilensis PS21 Using Riceberry Broken Rice, and Soybean Meal on Growth Performance, Immunity, and Resistance to Streptococcus agalactiae of Nile tilapia (Oreochromis niloticus). Animals, 13(20), 3262. https://doi.org/10.3390/ani13203262

